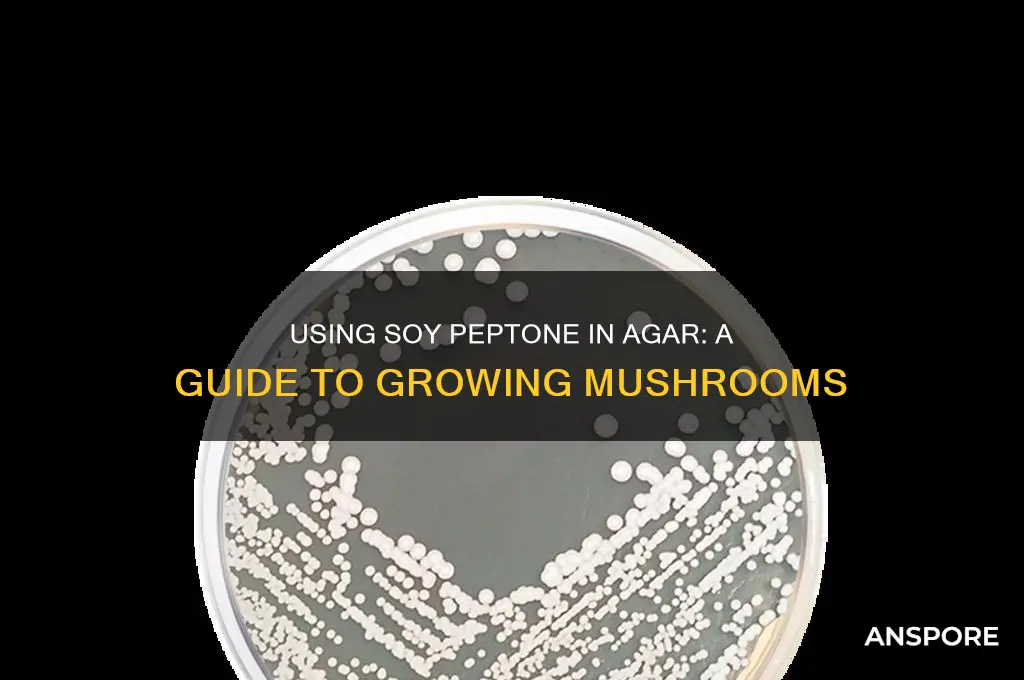
how to use soy peptone in agar forgrowing mushrooms

Soy peptone is a nutrient-rich, plant-based protein source commonly used in microbial and fungal cultivation, making it an excellent addition to agar-based substrates for growing mushrooms. When incorporated into agar, soy peptone provides essential amino acids, vitamins, and nitrogen compounds that promote mycelial growth and development. To use soy peptone effectively, it is typically mixed into a sterilized agar solution at a concentration of 1-2% (w/v) before pouring into petri dishes or other cultivation containers. This enriched agar medium supports robust mushroom mycelium colonization, particularly for species like *Pleurotus* (oyster mushrooms) and *Lentinula edodes* (shiitake). Proper sterilization and aseptic techniques are crucial to prevent contamination, ensuring the soy peptone agar provides an optimal environment for healthy mushroom growth.
| Characteristics | Values |
|---|---|
| Purpose | Soy peptone is used as a nitrogen source in agar media to promote mycelial growth of mushrooms. |
| Concentration | Typically used at concentrations ranging from 0.5% to 2% (w/v) in agar media. |
| Role | Provides essential amino acids, peptides, and nitrogenous compounds necessary for fungal growth. |
| Advantages | Cost-effective, readily available, and supports robust mycelial growth compared to some other nitrogen sources. |
| Preparation | Dissolve soy peptone in distilled water, sterilize by autoclaving (121°C, 15-20 minutes), and mix with molten agar before pouring plates. |
| pH Adjustment | Adjust the pH of the medium to 5.5-6.0, optimal for most mushroom species, before sterilization. |
| Sterilization | Autoclave the medium containing soy peptone to ensure sterility and prevent contamination. |
| Storage | Store prepared agar plates at 4°C for up to 4 weeks or until use. |
| Compatibility | Can be combined with other nutrients like glucose, vitamins, and minerals to create a complete growth medium. |
| Common Mushroom Species | Suitable for growing species like Agaricus bisporus (button mushroom), Pleurotus ostreatus (oyster mushroom), and Lentinula edodes (shiitake). |
| Contamination Risk | Ensure aseptic techniques during preparation to avoid bacterial or mold contamination. |
| Alternative Nitrogen Sources | Can be replaced with other peptones (e.g., casein peptone) or organic nitrogen sources if needed. |
Explore related products
What You'll Learn
- Soy Peptone Concentration: Optimal levels for mycelium growth without contamination
- Agar Preparation: Sterilizing agar with soy peptone for mushroom cultivation
- pH Adjustment: Balancing pH for enhanced mushroom growth using soy peptone
- Sterilization Techniques: Preventing contamination during soy peptone agar preparation
- Spawn Inoculation: Transferring mycelium to soy peptone agar for fruiting

Soy Peptone Concentration: Optimal levels for mycelium growth without contamination
Soy peptone, a nitrogen-rich compound derived from soybeans, is a critical component in agar-based substrates for mushroom cultivation. Its concentration directly influences mycelium growth rate, density, and resistance to contamination. However, too much can inhibit growth or promote bacterial proliferation, while too little may starve the mycelium. Finding the optimal concentration is a delicate balance, typically ranging between 0.5% to 2.0% (w/v) in agar formulations. This range provides sufficient nitrogen without overwhelming the substrate or creating a favorable environment for contaminants.
Analyzing the Impact of Concentration:
At 0.5%, soy peptone supports steady mycelium growth but may result in slower colonization, particularly for species with higher nitrogen demands like *Pleurotus ostreatus* (oyster mushrooms). Increasing the concentration to 1.0% often accelerates growth, as observed in *Agaricus bisporus* (button mushrooms), where mycelium density and vigor improve significantly. Beyond 1.5%, risks emerge: excessive nitrogen can lead to ammonia accumulation, which is toxic to mycelium, while the nutrient-rich environment attracts competing bacteria and molds. For example, a study on *Lentinula edodes* (shiitake mushrooms) found that 2.0% soy peptone consistently led to contamination within 7 days of inoculation.
Practical Guidelines for Optimal Use:
Start with a baseline concentration of 1.0% soy peptone in your agar substrate, as this is a safe midpoint for most mushroom species. For species known to thrive on higher nitrogen levels, such as *Flammulina velutipes* (enoki mushrooms), incrementally increase to 1.5% while monitoring for contamination. Conversely, species like *Hericium erinaceus* (lion’s mane), which prefer leaner substrates, may perform better at 0.75%. Always sterilize the agar thoroughly and work in a sterile environment to minimize contamination risks, especially at higher concentrations.
Cautions and Troubleshooting:
Avoid exceeding 2.0% soy peptone, as this almost invariably leads to contamination or mycelium stress. If contamination occurs, reduce the concentration and ensure proper sterilization techniques, such as using a pressure cooker for at least 30 minutes at 15 psi. Additionally, observe mycelium behavior: if growth is sluggish, increase the concentration slightly, but if the mycelium appears darkened or watery, reduce it. Regularly document results to refine your approach based on specific mushroom species and environmental conditions.
The optimal soy peptone concentration is species-dependent but generally falls between 0.5% to 1.5%. Start conservatively, experiment in small batches, and prioritize sterility to maximize mycelium growth while minimizing contamination. By fine-tuning this parameter, cultivators can create a robust agar substrate that supports healthy mycelium development and successful mushroom fruiting.
Mastering Mushroom Cultivation: A Guide to Using Agar Plates
You may want to see also

Agar Preparation: Sterilizing agar with soy peptone for mushroom cultivation
Sterilization is a critical step in agar preparation for mushroom cultivation, ensuring a contamination-free environment for mycelial growth. When incorporating soy peptone into agar, the process demands precision to maintain nutrient integrity while eliminating microbes. Typically, a 2-3% agar concentration is mixed with 0.5-1% soy peptone by weight, dissolved in distilled water, and heated to boiling. This mixture is then transferred to sterile containers, sealed, and subjected to autoclaving at 121°C (250°F) for 15-20 minutes. This method not only sterilizes the medium but also activates the soy peptone’s nitrogenous compounds, fostering robust mycelial development.
The choice of soy peptone as a nutrient source is deliberate, as it provides a balanced profile of amino acids and vitamins essential for mushroom mycelium. However, its organic nature makes it susceptible to degradation if overheated or exposed to prolonged sterilization. To mitigate this, avoid exceeding recommended autoclave times and ensure even heat distribution by using wide-mouth containers. Additionally, pre-sterilizing soy peptone separately before mixing with agar can reduce the risk of contamination, though this step is optional and depends on the cultivator’s preference.
A common pitfall in agar sterilization is inadequate sealing of containers, leading to microbial intrusion during cooling. Use autoclave-safe containers with secure lids or aluminum foil sealed with tape to maintain sterility. After sterilization, allow the agar to cool to 50-60°C (122-140°F) before pouring into Petri dishes or spawn jars to prevent condensation, which can introduce contaminants. Labeling containers with preparation dates and nutrient concentrations ensures traceability and consistency across cultivation batches.
Comparing soy peptone-enriched agar to traditional formulations, the former often yields faster colonization rates due to its readily available nitrogen sources. However, this advantage comes with the challenge of maintaining sterility, as richer media are more attractive to competing microbes. Cultivators should adopt stringent aseptic techniques, such as working in a laminar flow hood and using flame-sterilized tools, to maximize success. For beginners, starting with smaller batches allows for practice and refinement of the sterilization process before scaling up.
In conclusion, sterilizing agar with soy peptone for mushroom cultivation requires a blend of precision, patience, and attention to detail. By adhering to specific dosages, sterilization protocols, and post-sterilization practices, cultivators can create an optimal medium for mycelial growth. While the process may seem intricate, the rewards—healthier mycelium and higher mushroom yields—justify the effort, making it a valuable technique for both hobbyists and professionals.
Do Mushrooms Use Cellular Respiration? Exploring Fungal Energy Metabolism
You may want to see also

pH Adjustment: Balancing pH for enhanced mushroom growth using soy peptone
Mushroom mycelium thrives in a slightly acidic environment, typically with a pH range of 5.5 to 6.5. Soy peptone, a rich source of nitrogen and amino acids, can significantly influence the pH of your agar medium. Understanding and adjusting pH when using soy peptone is crucial for optimizing mushroom growth.
Unchecked pH levels can lead to slow colonization, contamination, or even mycelium death.
The Soy Peptone pH Factor: Soy peptone itself tends to be slightly alkaline. Incorporating it into your agar without pH adjustment can raise the overall pH, potentially creating an unfavorable environment for your mushroom species. This is especially critical for species like oyster mushrooms (Pleurotus ostreatus) which are particularly sensitive to pH fluctuations.
A simple pH test using strips or a meter before and after adding soy peptone will reveal the extent of the shift.
Precision Adjustment: Aim for a target pH within the optimal range for your chosen mushroom species. For most common culinary mushrooms, a pH of around 6.0 is a good starting point. To lower pH, gradually add small amounts of diluted phosphoric acid or citric acid, testing frequently to avoid overshooting. For slight increases, a pinch of calcium carbonate can be used, but exercise caution as it can affect nutrient availability.
Remember, small adjustments are key – a drastic pH change can be just as detrimental as an incorrect starting point.
Beyond the Numbers: pH adjustment isn't just about hitting a specific number. It's about creating a stable environment where your mycelium can flourish. Consider the buffering capacity of your agar – its ability to resist pH changes. Soy peptone itself can contribute to buffering, but additional buffering agents like potassium hydrogen phosphate may be necessary for long-term stability, especially in larger cultures.
Practical Tips for Success: Start with a reliable agar recipe specifically designed for mushroom cultivation. Source high-quality soy peptone from a reputable supplier to ensure consistency. Always sterilize your agar medium after pH adjustment to eliminate contaminants. Maintain sterile technique throughout the inoculation and incubation process. Observe your mycelium's growth rate and appearance – healthy mycelium should be white, fluffy, and rapidly colonizing the agar. If growth is slow or abnormal, revisit your pH and nutrient levels.
Does the Meollow Mushroom Use Vegetable Oil in Cooking?
You may want to see also
Explore related products

Sterilization Techniques: Preventing contamination during soy peptone agar preparation
Contamination is the arch-nemesis of successful mushroom cultivation, and soy peptone agar, a nutrient-rich medium, is particularly susceptible. Even a single stray spore or bacterium can derail your entire grow, turning your carefully prepared agar into a Petri dish of unwanted organisms. Sterilization, therefore, isn't just a step; it's the cornerstone of your success.
Think of it as a meticulous dance, where precision and attention to detail are paramount. Every surface, every tool, every ingredient must be treated as a potential carrier of contaminants.
The Autoclave: Your Sterilization Workhorse
The autoclave reigns supreme in the world of sterilization. This pressurized chamber utilizes steam heat to obliterate microorganisms, including spores, the most resilient of the bunch. For soy peptone agar, autoclaving is the gold standard. Aim for a temperature of 121°C (250°F) and a pressure of 15 psi for at least 15-20 minutes. This ensures complete sterilization, leaving your agar ready for inoculation. Remember, always follow the manufacturer's instructions for your specific autoclave model.
Beyond the Autoclave: When Autoclaving Isn't an Option
While ideal, autoclaving isn't always feasible. For those without access to this equipment, alternative methods exist, though they come with caveats. Pressure cooking can be used, but achieving consistent temperatures and pressure can be challenging. Aim for the same temperature and duration as autoclaving, but be aware that results may be less reliable.
The Art of Aseptic Technique: Your First Line of Defense
Even with sterilization, vigilance is key. Aseptic technique is the practice of minimizing the introduction of contaminants during the entire process. This includes working in a clean environment, using sterile tools, and employing proper handling techniques. Flame sterilization of inoculation loops and needles is crucial before and after each use. Wear gloves and a lab coat to minimize skin contact with the agar.
The Takeaway: A Sterile Environment is a Successful Environment
Sterilization is not a one-time event but a continuous process. From the moment you prepare your soy peptone agar to the final fruiting stage, maintaining a sterile environment is paramount. By combining autoclaving (or a suitable alternative) with meticulous aseptic technique, you create a safe haven for your mushroom mycelium to thrive, free from the threat of contamination. Remember, in the world of mushroom cultivation, cleanliness is not just next to godliness; it's the key to a bountiful harvest.
Exploring the Medical Potential of Mushrooms: Uses and Benefits
You may want to see also

Spawn Inoculation: Transferring mycelium to soy peptone agar for fruiting
Soy peptone agar serves as a nutrient-rich medium that bridges the gap between mycelial growth and fruiting, offering a controlled environment for mushrooms to transition from vegetative to reproductive stages. Spawn inoculation is a critical step in this process, where mature mycelium is transferred to soy peptone agar to initiate fruiting. This technique leverages the agar’s high protein and nitrogen content, which mimics the conditions of a natural substrate, encouraging the mycelium to form primordia—the precursors to mushroom fruiting bodies.
To begin, prepare soy peptone agar by dissolving 20 grams of soy peptone, 20 grams of agar, and 10 grams of dextrose in one liter of distilled water. Autoclave the mixture at 121°C for 20 minutes to sterilize it, then pour into Petri dishes or jars and allow it to solidify. Once cooled, select a healthy, fully colonized mycelium culture as your inoculant. Using a sterile scalpel or inoculation loop, excise a small piece (approximately 1 cm²) of mycelium from the culture, ensuring no contamination is introduced. Transfer this fragment to the center of the soy peptone agar, pressing it gently to ensure contact with the medium.
The success of spawn inoculation hinges on maintaining sterility and providing optimal conditions for mycelial adaptation. Incubate the inoculated agar at 22–25°C in a dark environment, monitoring for contamination daily. Within 7–14 days, the mycelium should fully colonize the agar, signaling readiness for fruiting. At this stage, introduce environmental triggers such as light, humidity, and temperature fluctuations to stimulate primordia formation. For example, exposing the agar to 12 hours of indirect light and maintaining 90% humidity can accelerate fruiting.
Comparatively, soy peptone agar offers advantages over traditional grain or sawdust substrates for spawn inoculation. Its semi-solid consistency allows for better oxygen exchange and nutrient accessibility, fostering faster mycelial growth. Additionally, its clarity enables visual monitoring of mycelial health and contamination. However, it requires precise sterilization and handling to avoid bacterial or mold intrusion, which can outcompete the mycelium.
In practice, this method is particularly effective for gourmet mushroom species like *Pleurotus ostreatus* (oyster mushrooms) and *Lentinula edodes* (shiitake), which respond well to high-nitrogen environments. For hobbyists, it provides a scalable, controlled pathway to fruiting, while commercial growers can use it to produce consistent, high-quality spawn. By mastering spawn inoculation on soy peptone agar, cultivators can streamline the transition from mycelial growth to fruiting, maximizing yield and minimizing risk.
Boost Veggie Growth: Using Mushroom Compost in Raised Garden Beds
You may want to see also
Frequently asked questions
Soy peptone is a nutrient-rich, water-soluble protein derived from soybeans. It is used in agar for growing mushrooms because it provides essential nitrogen, amino acids, and vitamins that support mycelial growth and development.
Typically, 10–20 grams of soy peptone per liter of agar is recommended. However, the exact amount may vary depending on the mushroom species and specific recipe, so experimentation is advised.
Yes, soy peptone can be substituted with other nitrogen sources like yeast extract, casein hydrolysate, or wheat germ, but results may vary. Soy peptone is preferred for its balanced nutrient profile and cost-effectiveness.

























